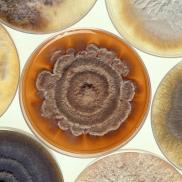
CultureWS Photo

About
Experience an unforgettable evening in downtown Winston-Salem, where vibrant atmosphere meets exceptional cuisine. This destination offers a thoughtfully curated menu centered on authentic Thai flavors, elevated with a modern culinary twist. Guests can savor traditional favorites prepared with care,or explore innovative new dishes that bring fresh creativity to the table.
In addition to its standout Thai offerings, the menu features a variety of Asian-inspired selections, including expertly crafted sushi. A well-rounded beverage program complements the dining experience, with a range of alcoholic options designed to pair perfectly with the bold and nuanced flavors of the cuisine, and a Sunday Thai brunch.
Whether seeking classic comfort dishes or contemporary interpretations, this dining experience delivers both quality and variety in a refined, welcoming setting—ideal for a memorable night out in the heart of the city.